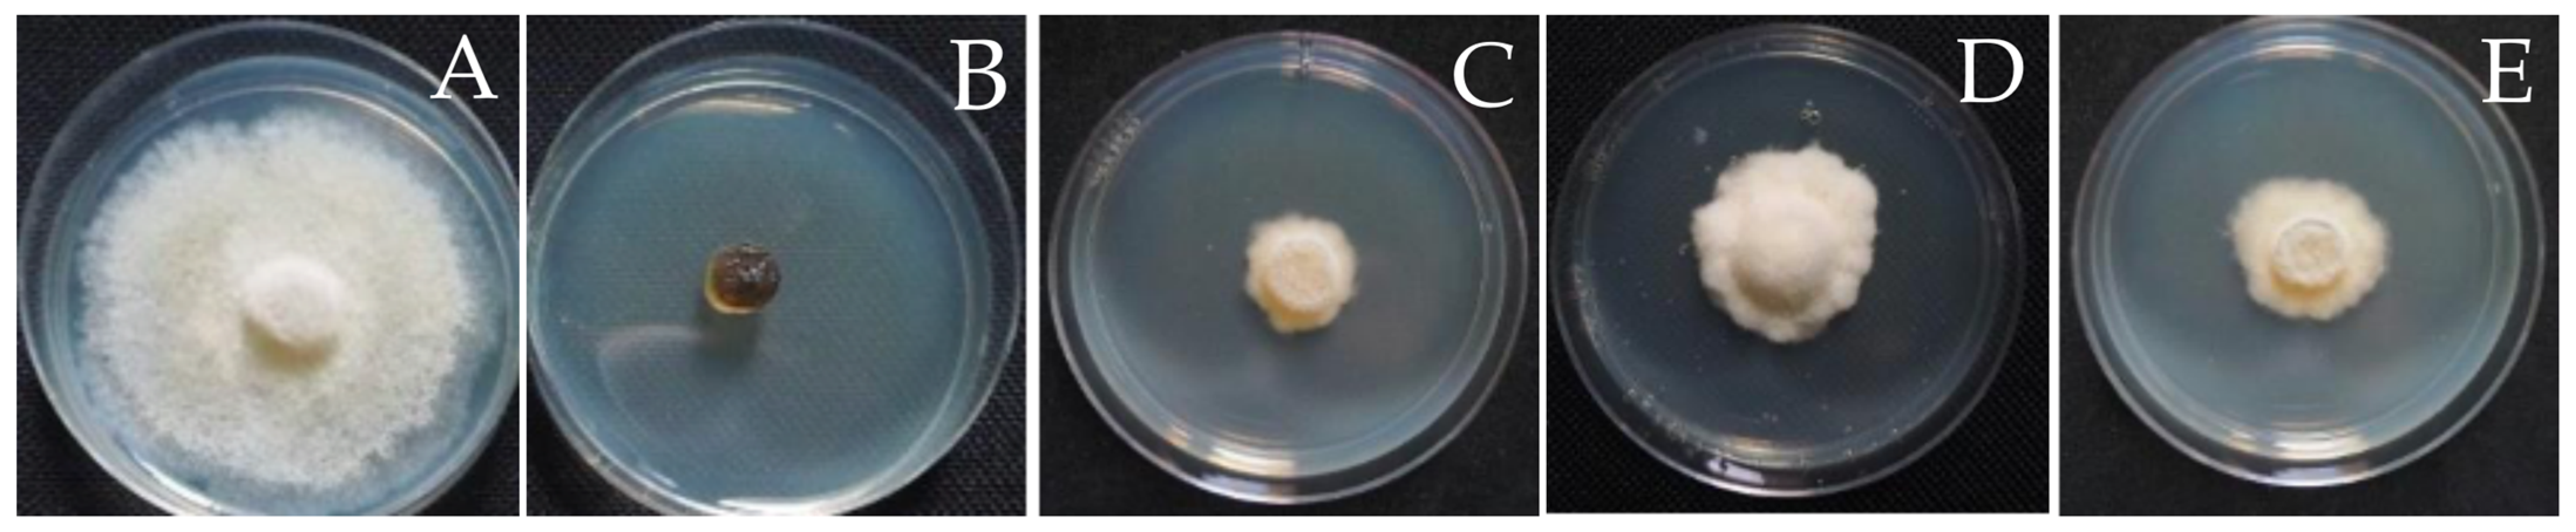
Jof 09 01191 g004
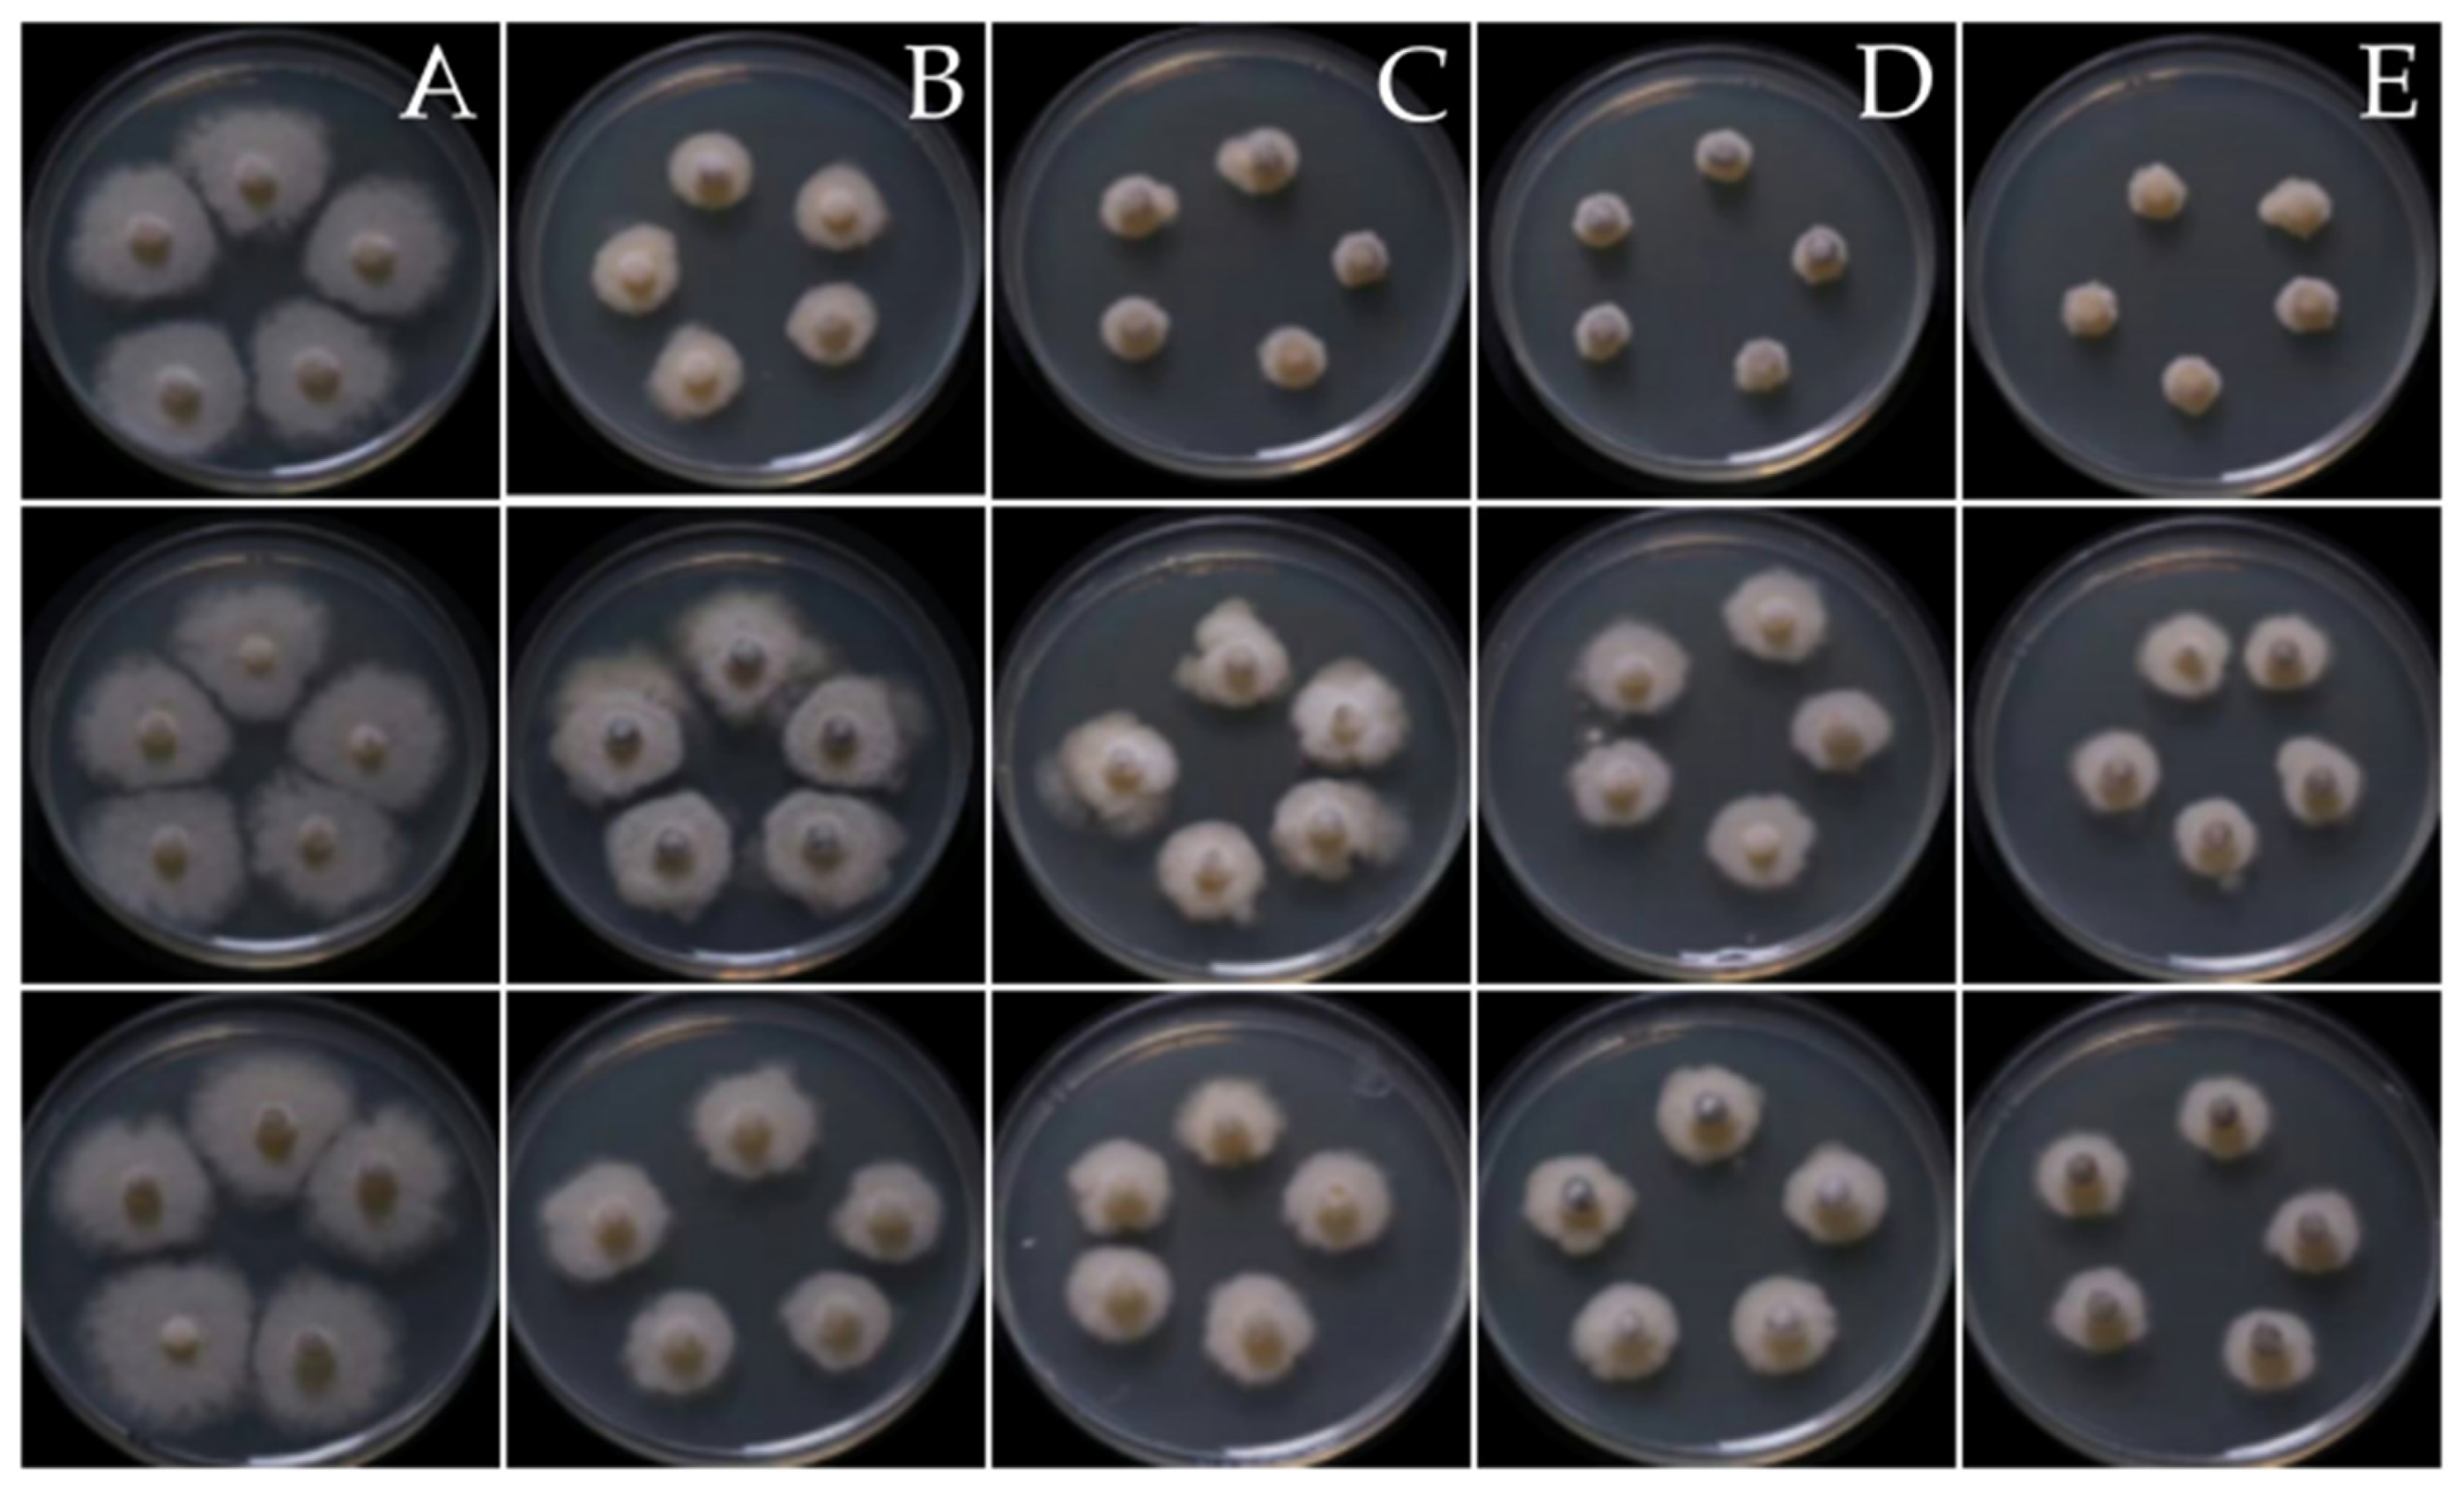
Jof 09 01191 g005

Diversity and Advantages of Culturable Endophytic Fungi from Tea (Camellia sinensis)
Abstract
:1. Introduction
2. Materials and Methods
2.1. Identification and Isolation of Endophytes
2.2. Characterization, Phylogenetic Analysis, and Diversity Index
2.3. IAA Production in Endophytic Fungi
2.4. Determination of Phosphate Solubilization
2.5. Extraction of Fungal Crude Extract
2.6. In Vitro Assay
2.6.1. Disc Diffusion Assay
2.6.2. Poisoned Food Assay
2.6.3. IC50
2.7. In Vivo Assay
2.7.1. Detach Leave Assay
2.7.2. Greenhouse Evaluation
2.8. Statistical Analyses
3. Results
3.1. Endophyte Identification and Distribution across Plant Tissues
3.2. Community Composition between Organic and Conventional System
3.3. IAA Production and Determination of Phosphate Solubilization
3.4. Antifungal Activity of the Fungal Endophytes
4. Discussion
Supplementary Materials
Author Contributions
Funding
Institutional Review Board Statement
Informed Consent Statement
Data Availability Statement
Acknowledgments
Conflicts of Interest
References
- Collinge, D.B.; Jensen, B.; Jørgensen, H.J. Fungal endophytes in plants and their relationship to plant disease. Curr. Opin. Microbiol. 2022, 69, 102177. [Google Scholar] [CrossRef]
- Rodriguez, R.J.; White, J.F.; Arnold, A.E.; Redman, R.S. Fungal endophytes: Diversity and functional roles. New Phytol. 2009, 182, 314–330. [Google Scholar] [CrossRef]
- Kusari, S.; Verma, V.C.; Lamshoeft, M.; Spiteller, M. An endophytic fungus from Azadirachta indica A. Juss. that produces azadirachtin. World J. Microbiol. Biotechnol. 2012, 28, 1287–1294. [Google Scholar] [CrossRef]
- Núñez, G.; Lisbel, B.R.; Da, S.; Evelyn, C.G.; Cosoveanu, A.; Brito, N. Endophytic fungi from Vitis vinifera L. isolated in Canary Islands and Azores as potential biocontrol agents of Botrytis cinerea Pers.:Fr. J. Hortic. For. Biotechnol. 2012, 16, 1–6. [Google Scholar]
- Yang, H.; Ye, W.; Ma, J.; Zeng, D.; Rong, Z.; Xu, M.; Wang, Y.; Zheng, X. Endophytic fungal communities associated with field-grown soybean roots and seeds in the Huang-Huai region of China. PeerJ 2018, 6, e4713. [Google Scholar] [CrossRef]
- Zhang, J.; Zhu, Y.; Si, J.; Wu, L. Metabolites of medicine food homology-derived endophytic fungi and their activities. Curr. Res. Food Sci. 2022, 5, 1882–1896. [Google Scholar] [CrossRef]
- Zheng, Y.K.; Qiao, X.G.; Miao, C.P. Diversity, distribution and biotechnological potential of endophytic fungi. Ann. Microbiol. 2016, 66, 529–542. [Google Scholar] [CrossRef]
- Zheng, R.; Li, S.; Zhang, X.; Zhao, C. Biological activities of some new secondary metabolites isolated from endophytic fungi: A review study. Int. J. Mol. Sci. 2021, 22, 959. [Google Scholar] [CrossRef] [PubMed]
- Calvo, A.M.; Wilson, R.A.; Bok, J.W.; Keller, N.P. Relationship between secondary metabolism and fungal development. Microbiol. Mol. Biol. 2002, 66, 447–459. [Google Scholar] [CrossRef] [PubMed]
- Nagarajan, K.; Ibrahim, B.; Ahmad, B.A.; Lim, J.W.; Tong, W.Y.; Leong, C.R.; Khaw, K.Y.; Tan, W.N. Recent developments in metabolomics studies of endophytic fungi. J. Fungi 2021, 8, 28. [Google Scholar] [CrossRef]
- Redman, R.S.; Dunigan, D.D.; Rodriguez, R.J. Fungal symbiosis from mutualism to parasitism: Who controls the outcome, host or invader? New Phytol. 2001, 151, 705–716. [Google Scholar] [CrossRef] [PubMed]
- Hamzah, T.N.T.; Lee, S.Y.; Hidayat, A.; Terhem, R.; Faridah-Hanum, I.; Mohamed, R. Diversity and characterization of endophytic fungi isolated from the tropical mangrove species, Rhizophora mucronata, and identification of potential antagonists against the soil-borne fungus, Fusarium solani. Front. Microbiol. 2018, 9, 1707. [Google Scholar] [CrossRef] [PubMed]
- Russo, M.L.; Pelizza, S.A.; Cabello, M.N.; Stenglein, S.A.; Vianna, M.F.; Scorsetti, A.C. Endophytic fungi from selected varieties of soybean (Glycine max L. Merr.) and corn (Zea mays L.) grown in an agricultural area of Argentina. Rev. Argen. 2016, 48, 154–160. [Google Scholar] [CrossRef] [PubMed]
- Al-Harthi, H.F.; Elgorgan, A.M.; Ahmed, B.; Bahkali, A.H.; ElSheshtawi, M.; Shaik, J.P.; Al-Falih, A.M.; Syed, A. Identification, molecular characterization, and plant growth promoting activities of endophytic fungi of Jasminum sambac, Camellia sinensis, and Ocimum basilicum. J. King Saud Univ. Sci. 2023, 35, 102558. [Google Scholar] [CrossRef]
- Dai, C.C.; Yu, B.Y.; Xu, Z.L.; Yuan, S. Effect of environmental factors on growth and fatty acid composition of five endophytic fungi from Sapium sebiferum. J. Appl. Ecol. 2003, 14, 1525–1528. [Google Scholar]
- Dastager, S.G.; Deepa, C.K.; Pandey, A. Isolation and characterization of novel plant growth promoting Micrococcus sp NII-0909 and its interaction with cowpea. Plant Physiol. Biochem. 2010, 48, 987–992. [Google Scholar] [CrossRef] [PubMed]
- Ismail, I.; Hamayun, M.; Hussain, A.; Iqbal, A.; Afzal Khan, S.; Lee, I. Endophytic fungus Aspergillus japonicus mediates host plant growth under normal and heat stress conditions. BioMed Res. Int. 2018, 2018, 7696831. [Google Scholar] [CrossRef]
- Bandre, T.R.; Sasek, V. Antibiotic activity of pyrenomycetes under submerged conditions. Folia Microbiol. 1977, 22, 269–274. [Google Scholar] [CrossRef]
- Dini-Andreote, F. Endophytes: The second layer of plant defense. Trends Plant Sci. 2020, 25, 319–322. [Google Scholar] [CrossRef]
- Ogbe, A.A.; Finnie, J.F.; Staden, J.V. The role of endophytes in secondary metabolites accumulation in medicinal plants under abiotic stress. S. Afr. J. Bot. 2020, 134, 126–134. [Google Scholar] [CrossRef]
- Macías-Rubalcava, M.; Garrido-Santos, M. Phytotoxic compounds from endophytic fungi. Appl. Microbiol. Biotechnol. 2022, 106, 931–950. [Google Scholar] [CrossRef] [PubMed]
- Ramos, G.C.; Silva-Silva, J.V.; Watanabe, L.A.; Siqueira, J.E.S.; Almeida-Souza, F.; Calabrese, K.S.; Marinho, A.M.R.; Marinho, P.S.B.; Oliveira, A.S. Phomoxanthone A, Compound of endophytic fungi Paecilomyces sp. and its potential antimicrobial and antiparasitic. J. Antibiot. 2022, 11, 1332. [Google Scholar] [CrossRef] [PubMed]
- Bae, S.; Mohanta, T.K.; Chung, J.Y.; Ryu, M.; Park, G.; Shim, S.; Hong, S.; Seo, H.; Bae, D.; Bae, I.; et al. Trichoderma metabolites as biological control agents against Phytophthora pathogens. Biol. Control 2016, 92, 28–138. [Google Scholar] [CrossRef]
- Zhang, G.; Zhang, Y.; Qin, J.; Qu, X.; Liu, J.; Li, X.; Pan, H. Antifungal metabolites produced by Chaetomium globosum No. 04, an endophytic fungus isolated from Ginkgo biloba. Indian J. Microbiol. 2013, 53, 175–180. [Google Scholar] [CrossRef] [PubMed]
- Li, P.F.; Ren, R.S.; Yao, X.F.; Xu, J.H.; Babu, B.; Paret, M.L.; Yang, X.P. Identification and characterization of the causal agent of gummy stem blight from muskmelon and watermelon in east China. J. Phytopathol. 2015, 163, 314–319. [Google Scholar] [CrossRef]
- Gusmini, G.; Luis, R.; Wehner, T. Inheritance of resistance to gummy stem blight in watermelon. Hort. Sci. 2017, 52, 1477–1482. [Google Scholar] [CrossRef]
- Komárek, M.; Čadková, E.; Chrastný, V.; Bordas, F.; Bollinger, J.C. Contamination of vineyard soils with fungicides: A review of environmental and toxicological aspects. Environ. Int. 2010, 36, 138–151. [Google Scholar] [CrossRef]
- Ren, H.; Wang, H.; Wang, Q.; Qi, X.; Zhang, S.; Yu, Z.; Ijaz, M.; Zhang, M.; Ahmed, T.; El-Sharnouby, M.; et al. Effect of fungicides on bayberry decline disease by modulating rhizosphere soil properties, microflora, and metabolites. J. Agron. 2022, 12, 677. [Google Scholar] [CrossRef]
- Thambugala, K.; Daranagama, D.; Kannangara, S. Biocontrol potential of endophytic fungi in tea (Camellia sinensis (L.) Kuntze) leaves against selected fungal phytopathogens. Malays. J. Microbiol. 2022, 18, 665–669. [Google Scholar] [CrossRef]
- Zhu, X.J.; Hu, Y.F.; Chen, X.; Wang, Y.H.; Fang, W.P.; Li, X.H. Endophytic fungi from Camellia sinensis show an antimicrobial activity against the rice blast pathogen Magnaporthe grisea. Phyton 2014, 83, 57–63. [Google Scholar]
- Nath, R.; Sharma, G.D.; Barooah, H. Plant growth promoting endophytic fungi isolated from tea (Camellia sinensis) shrubs of Assam, India. Appl. Ecol. Environ. Res. 2015, 13, 877–891. [Google Scholar]
- Win, P.M.; Matsumura, E.; Fukuda, K. Diversity of tea endophytic fungi: Cultivar- and tissue preferences. Appl. Ecol. Environ. Res. 2018, 16, 677–695. [Google Scholar] [CrossRef]
- Umesha, S.; Manukumar, H.M.; Raghava, S. A rapid method for isolation of genomic DNA from food-borne fungal pathogens. Biotechnol. J. 2016, 6, 123. [Google Scholar] [CrossRef] [PubMed]
- White, T.J. Amplification and direct sequencing of fungal ribosomal RNA genes for phylogenetics. In PCR Protocols, a Guide to Methods and Applications; Academic Press: New York, NY, USA, 1990; pp. 315–322. [Google Scholar]
- Kumar, S.; Stecher, G.; Tamura, K. MEGA7: Molecular evolutionary genetics analysis version 7.0 for bigger datasets. Mol. Biol. Evol. 2016, 33, 1870–1874. [Google Scholar] [CrossRef] [PubMed]
- Tamura, K.; Stecher, G.; Peterson, D. MEGA6: Molecular Evolutionary Genetics Analysis, Version 6.0; The Society for Molecular Biology and Evolution; Oxford University: Oxford, UK, 2013. [Google Scholar]
- Posada, D.; Crandall, K.A. Modeltest: Testing the model of DNA substitution. J. Bioinform. 1998, 14, 817–818. [Google Scholar] [CrossRef]
- Ronquist, F.; Teslenko, M.; van der Mark, P.; Ayres, D.L.; Darling, A.; Höhna, S.; Larget, B.; Liu, L.; Suchard, M.A.; Huelsenbeck, J.P. MrBayes 3.2: Efficient Bayesian phylogenetic inference and model choice across a large model space. Syst. Biol. 2012, 61, 539–542. [Google Scholar] [CrossRef] [PubMed]
- An, C.; Ma, S.; Shi, X.; Xue, W.; Liu, C.; Ding, H. Isolation, diversity, and antimicrobial activity of fungal endophytes from Rohdea chinensis (Baker) N. Tanaka (synonym Tupistra chinensis Baker) of Qinling Mountains, China. PeerJ 2020, 17, e9342. [Google Scholar] [CrossRef]
- Bråthen, K.A.; Jahiri, X.; Jusdado, J.G.H.; Soininen, E.M.; Jensen, J.B. Fungal endophyte diversity in tundra grasses increases by grazing. Fungal Ecol. 2015, 17, 41–51. [Google Scholar] [CrossRef]
- Liu, H.; Tao, G.; Liu, Z.Y.; Zhu, Y. Diversity analysis of endophytic fungi associated with Bletilla ochracea (Orchidaceae). Mycosystema 2013, 32, 812–818. [Google Scholar]
- Premono, M.E.; Moawad, A.M.; Vlek, P.L.G. Effect of phosphate-solubilizing Pseudomonas putida on the growth of maize and its survival in the rhizosphere. Indones. J. Crop Sci. 1996, 11, 13. [Google Scholar]
- Verma, A.; Shameem, N.; Jatav, H.S.; Sathyanarayana, E.; Parray, J.A.; Poczai, P.; Sayyed, R.Z. Fungal endophytes to combat biotic and abiotic stresses for climate-smart and sustainable agriculture. Front. Plant Sci. 2022, 13, 953836. [Google Scholar] [CrossRef]
- Asad, S.; Priyashantha, A.K.H.; Tibpromma, S.; Luo, Y.; Zhang, J.; Fan, Z.; Zhao, L.; Shen, K.; Niu, C.; Lu, L.; et al. Coffee-associated endophytes: Plant growth promotion and crop protection. Biology 2023, 12, 911. [Google Scholar] [CrossRef]
- Dhayanithy, G.; Subban, K.; Chelliah, J. Diversity and biological activities of endophytic fungi associated with Catharanthus roseus. BMC Microbiol. 2019, 2019, 22. [Google Scholar] [CrossRef]
- Hernández-Ramírez, F.; Damon, A.; Fernández Pavía, S.P.; Guillén-Navarro, K.; Iracheta-Donjuan, L.; Zarza, E.; Castro-Chan, R.A. Community richness and diversity of endophytic fungi associated with the orchid Guarianthe skinneri infested with “Black Blotch” in the Soconusco Region, Chiapas, Mexico. Diversity 2023, 15, 807. [Google Scholar] [CrossRef]
- Yeh, Y.H.; Kirschner, R. Diversity of endophytic fungi of the coastal plant Vitex rotundifolia in Taiwan. Microbes Environ. 2019, 34, 59–63. [Google Scholar] [CrossRef]
- Xia, Y.; Sahib, M.R.; Amna, A. Culturable endophytic fungal communities associated with plants in organic and conventional farming systems and their effects on plant growth. Sci. Rep. 2019, 9, 1669. [Google Scholar] [CrossRef] [PubMed]
- Radić, T.; Likar, M.; Hančević, K.; Bogdanović, I.; Pasković, I. Occurrence of root endophytic fungi in organic versus conventional vineyards on the Croatian coast. Agric. Ecosyst. Environ. 2014, 192, 115–121. [Google Scholar] [CrossRef]
- Camatti-Sartori, V.; Silva-Ribeiro, R.T.; Valdebenito-Sanhueza, R.M.; Pagnocca, F.C.; Echeverrigaray, S.; Azevedo, J.L. Endophytic yeasts and filamentous fungi associated with southern Brazilian apple (Malus domestica) orchards subjected to conventional, integrated or organic cultivation. J. Basic Microbiol. 2005, 45, 397–402. [Google Scholar] [CrossRef] [PubMed]
- Win, P.M.; Matsumura, E.; Fukuda, K. Effects of pesticides on the diversity of endophytic fungi in tea plants. Microb. Ecol. 2021, 82, 62–72. [Google Scholar] [CrossRef] [PubMed]
- Lin, H.; Liu, C.; Peng, Z.; Tan, B.; Wang, K.; Liu, Z. Distribution pattern of endophytic bacteria and fungi in tea plants. Front. Microbiol. 2022, 13, 872034. [Google Scholar] [CrossRef]
- Abramczyk, B.; Marzec-Grządziel, A.; Grządziel, J.; Król, E.; Gałązka, A.; Oleszek, W. Biocontrol potential and catabolic profile of endophytic Diaporthe eres strain 1420S from Prunus domestica L. in Poland—A Preliminary Study. Agronomy 2022, 12, 165. [Google Scholar] [CrossRef]
- Cheng, Z.S.; Tang, W.C.; Xu, S.L. First report of an endophyte (Diaporthe phaseolorum var. sojae) from Kandelia candel. J. For. Res. 2008, 19, 277–282. [Google Scholar] [CrossRef]
- Gomes, R.R.; Glienke, C.; Videira, S.I.; Lombard, L.; Groenewald, J.Z.; Crous, P.W. Diaporthe: A genus of endophytic, saprobic and plant pathogenic fungi. Persoonia 2013, 31, 1–41. [Google Scholar] [CrossRef]
- Hilário, S.; Gonçalves, M.F.M. Endophytic Diaporthe as promising leads for the development of biopesticides and biofertilizers for a sustainable agriculture. Microorganisms 2022, 10, 2453. [Google Scholar] [CrossRef]
- Isaka, M.; Jaturapat, A.; Rukseree, K.; Danwisetkanjana, K.; Tanticharoen, M.; Thebtaranonth, Y. Phomoxanthones A and B, novel xanthone dimers from the endophytic fungus Phomopsis species. J. Nat. Prod. 2001, 64, 1015–1018. [Google Scholar] [CrossRef]
- Dettrakul, S.; Kittakoop, P.; Isaka, M.; Nopichai, S.; Suyarnsestakorn, C.; Tanticharoen, M.; Thebtaranonth, Y. Antimycobacterial pimarane diterpenes from the fungus Diaporthe sp. Bioorganic Med. Chem. Lett. 2003, 13, 1253–1255. [Google Scholar] [CrossRef] [PubMed]
- Kumaran, R.S.; Hur, B.K. Screening of species of the endophytic fungus Phomopsis for the production of the anticancer drug taxol. Biotechnol. Appl. Biochem. 2009, 54, 21–30. [Google Scholar] [CrossRef] [PubMed]
- Lin, X.; Huang, Y.; Fang, M.; Wang, J.; Zheng, Z.; Su, W. Cytotoxic and antimicrobial metabolites from marine lignicolous fungi, Diaporthe sp. FEMS Microbiol. Lett. 2005, 251, 53–58. [Google Scholar] [CrossRef] [PubMed]
- Xia, Y.; DeBolt, S.; Dreyer, J.; Scott, D.; Williams, M.A. Characterization of culturable bacterial endophytes and their capacity to promote plant growth from plants grown using organic or conventional practices. Front. Plant Sci. 2015, 6, 490. [Google Scholar] [CrossRef] [PubMed]

| Species Richness | Evenness | Abundance | Shannon’s (H) | Simpson’s (λ) | |
|---|---|---|---|---|---|
| Plant tissue | |||||
| Young leaves | 7 | 0.66 | 15 | 1.78 | 0.87 |
| Old leaves | 7 | 0.56 | 17 | 1.61 | 0.77 |
| Stem | 11 | 0.72 | 20 | 2.18 | 0.91 |
| Root | 10 | 0.84 | 14 | 2.21 | 0.95 |
| Cultivation system | |||||
| Organic system | 16 | 0.83 | 41 | 2.54 | 1.07 |
| Conventional system | 11 | 0.92 | 25 | 1.99 | 0.84 |
| Code | IAA Production (µg/mL) * | Phosphate (µg/mL) | |
|---|---|---|---|
| 3 Days | 6 Days * | ||
| Pleosporales sp., SO-006 | 0.65 ± 0.06 a | 3.60 ± 0.33 | 3.84 ± 0.32 b |
| Cladosporium sp., SO-022 | 0.15 ± 0.03 c | 3.53 ± 0.33 | 3.35 ± 0.45 b |
| Pleosporales sp., RO-013 | 0.17 ± 0.03 c | 2.70 ± 0.81 | 5.17 ± 1.03 a |
| Phaeosphaeriopsis sp., YO-002 | 0.16 ± 0.05 c | 3.43 ± 0.72 | 3.76 ± 0.85 b |
| Phaeosphaeriopsis sp., YO-008 | 0.27 ± 0.04 b | 3.10 ± 0.38 | 3.88 ± 0.77 b |
| Cladosporium sp., YO-020 | 0.19 ± 0.04 c | 2.89 ± 0.54 | 4.03 ± 0.41 ab |
| Fungal Crude Extract/Fungicide | Disc Diffusion Assay [Inhibition Zone (cM)] * | Poisoned Food Assay (% Mycelium Inhibition) ** |
|---|---|---|
| Carbendazim | 0.43 ± 0.05 ab | 94.66 ± 2.34 a |
| Diaporthe sp., YI-002 | 0.27 ± 0.05 c | 65.96 ± 6.57 d |
| Diaporthe sp., YI-005 | 0.52 ± 0.07 a | 88.54 ± 2.27 ab |
| Pleosporales sp., YI-008 | 0.32 ± 0.07 bc | 73.28 ± 2.33 c |
| Neopestalotiopsis sp., YI-102 | 0.41 ± 0.08 ab | 41.99 ± 5.90 f |
| Pseudopestalotiopsis sp., OI-018 | 0.33 ± 0.05 bc | 49.64 ± 0.86 e |
| Pseudopestalotiopsis sp., OI-019 | 0.23 ± 0.05 c | 59.21 ± 4.95 d |
| Neopestalotiosis sp., SI-002 | 0.42 ± 0.07 ab | 62.20 ± 5.56 d |
| Diaporthe sp., SI-007 | 0.33 ± 0.05 bc | 88.16 ± 1.10 ab |
| Eurotium sp., RI-008 | 0.32 ± 0.07 bc | 85.89 ± 2.56 b |
| Ovatospora sp., RI-012 | 0.33 ± 0.05 bc | 35.02 ± 5.67 f |
| Treatment | Melon Disease Severity (%) | |||
|---|---|---|---|---|
| 5DAI * | 7DAI * | 9DAI * | 11DAI * | |
| Untreated | 31.67 ± 3.32 a | 48.32 ± 13.43 a | 59.65 ± 1.39 a | 70.10 ± 3.00 a |
| Carbendazim | 10.58 ± 0.91 b | 30.77 ± 8.85 b | 34.08 ± 10.99 b | 42.16 ± 18.08 b |
| Diaporthe sp., YI-005 | 13.27 ± 4.37 b | 24.77 ± 9.63 b | 28.81 ± 7.88 b | 38.18 ± 1.59 b |
| Diaporthe sp., SI-007 | 13.89 ± 4.81 b | 28.35 ± 7.78 b | 33.55 ± 3.42 b | 43.74 ± 11.69 b |
| Eurotium sp., RI-008 | 11.73 ± 2.58 b | 27.31 ± 6.26 b | 37.13 ± 2.12 b | 42.16 ± 2.86 b |
Disclaimer/Publisher’s Note: The statements, opinions and data contained in all publications are solely those of the individual author(s) and contributor(s) and not of MDPI and/or the editor(s). MDPI and/or the editor(s) disclaim responsibility for any injury to people or property resulting from any ideas, methods, instructions or products referred to in the content. |
© 2023 by the authors. Licensee MDPI, Basel, Switzerland. This article is an open access article distributed under the terms and conditions of the Creative Commons Attribution (CC BY) license (https://creativecommons.org/licenses/by/4.0/).
Share and Cite
Onlamun, T.; Boonthavee, A.; Brooks, S. Diversity and Advantages of Culturable Endophytic Fungi from Tea (Camellia sinensis). J. Fungi 2023, 9, 1191. https://doi.org/10.3390/jof9121191
Onlamun T, Boonthavee A, Brooks S. Diversity and Advantages of Culturable Endophytic Fungi from Tea (Camellia sinensis). Journal of Fungi. 2023; 9(12):1191. https://doi.org/10.3390/jof9121191
Chicago/Turabian StyleOnlamun, Thanyarat, Autchima Boonthavee, and Siraprapa Brooks. 2023. "Diversity and Advantages of Culturable Endophytic Fungi from Tea (Camellia sinensis)" Journal of Fungi 9, no. 12: 1191. https://doi.org/10.3390/jof9121191
APA StyleOnlamun, T., Boonthavee, A., & Brooks, S. (2023). Diversity and Advantages of Culturable Endophytic Fungi from Tea (Camellia sinensis). Journal of Fungi, 9(12), 1191. https://doi.org/10.3390/jof9121191





